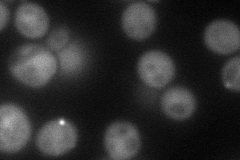
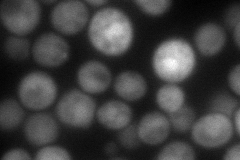
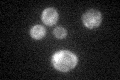

View description
Glycogen synthase with similarity to Gsy2p, the more highly expressed yeast homolog; expression induced by glucose limitation, nitrogen starvation, environmental stress, and entry into stationary phase
Localization:
Intensity:
Fold change:
Significance:
-
C’ GFP library in SD

punctate:cytosol47.32 -
N' NOP1pr-GFP in SD
cytosol,punctate81.3359 -
N' TEF2pr-mCherry in SD
cytosol,punctate103.686 -
N' NATIVEpr-GFP in SD

punctate32.6006 -
N' TEF2pr-VC and Cyto-VN in SD

cytosol,punctate,nucleus47.8528 -
C’ GFP library in SD+DTT

punctate.cytosol61.691.3No -
C’ GFP library in SD+H2O2

punctate.cytosol47.260.99No -
C’ GFP library in Starvation Media
punctate,cytosol29.190.61Yes -
C’ GFP library on the background of Pup2-DaMP

punctate:cytosol -
C’ GFP library on the background of CCT mutant

punctate:cytosol46.39750.980293No
